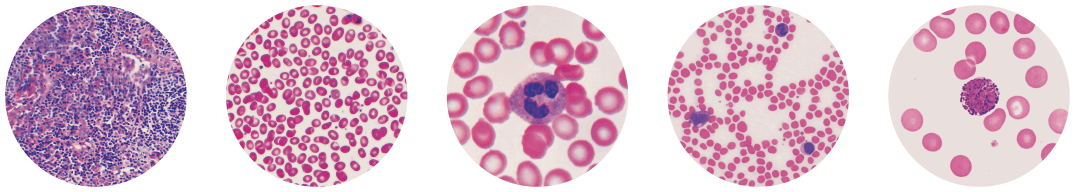

LA DIAGNOSTICA IN FARMACIA
Con noi la sicurezza di fare sempre bene

Scegli di lavorare in serenità Scegli i servizi Voden
Scegliere Voden significa scegliere il meglio per la tua farmacia, i tuoi pazienti e il futuro del tuo business. Con Voden hai a disposizione un percorso concreto fatto di soluzioni diagnostiche avanzate, formazione continua e strumenti che semplificano il lavoro, rafforzando il tuo ruolo di primo riferimento sanitario sul territorio.
Oggi Voden fa un nuovo passo avanti nella diagnostica di prima istanza NPT con le versioni evolute di Vxell® 4.0 e VchemyS® 4.0


ALL in ONE
Vxell® FIVE 4.0, il nostro analizzatore ematologico automatico con formula completa a 5 popolazioni e modulo a fluorescenza per CRP e SAA, che integra l’analisi morfologica delle cellule supportata dall’Intelligenza Artificiale per risultati precisi in appena 7 minuti.
Grazie alla tecnologia robotizzata “zero step”, offre un’esperienza semplice e intuitiva per l’operatore, con alta affidabilità e costi contenuti, rendendolo la soluzione ideale per la Farmacia evoluta.


VchemyS® EVO 4.0, nato dal successo del modello precedente che utilizza rotori interi con ampi profili, mantiene gli stessi benefici, ma introduce innovativi rotori a spicchi che offrono una maggiore flessibilità nella combinazione di parametri analitici e di conseguenza un’aumentata convenienza per la Farmacia. Grazie alla segmentazione in spicchi, il volume di prelievo richiesto si riduce a soli 60 uL.
VXELL FIVE
Finalmente l’emocromo che fa la differenza
Conta quello che si vede. Da oggi anche eosinofili e basofili
Grazie alla microscopia digitale HD supportata dall’Intelligenza artificiale, la diagnostica ematologica NPT evolve e diventa LabGrade!


Risultati affidabili in tempi record
Risultati in solo 7 minuti.

affidabile come in laboratorio
Finalmente, con Vxell FIVE 4.0 l’emocromo in farmacia raggiunge livelli di precisione e affidabilità pari a quelli che si ottengono in un laboratorio di analisi.

25 parametri ematologici
i vantaggi di Vxell® FIVE 4.0
per te farmacista.

zero manutenzione
calibrazione e controlli automatici

Plug and play
si accende solo quando serve

calibrazione e controllo
sono automatici

economicità di servizio
i reagenti scadono dopo 2 anni

elevata connettività
WIFI, LAN, USB

Tranquillità del servizio
Assistenza Tecnica online con VODEN EASYNET
i benefici di Vxell® FIVE 4.0
per i tuoi utenti.

rapida accesibilità
senza perdere tempo per prenotare e risultati in pochi minuti

comodità e famigliarità
con l’ambiente farmacia e i farmacisti

SICUREZZA DEI RISULTATI
garanzia per ogni decisione medica

Riduzione dello stress
dell’ansia dovuti all’attesa e al prelievo venoso Digitopuntura meno invasiva
Vxell® FIVE 4.0 VI PROIETTA NEL FUTURO | ALL in ONE
MICROSCOPIA DIGITALE | MODULO A FLUORESCENZA | MODULO FOTOMETRICO*
Analizzatore automatico All-in-one per emocromo con formula completa a 5 popolazioni, basato sull’analisi morfologica delle cellule supportata dall’intelligenza artificiale e completo di Modulo FIA per CRP/SAA e molto altro.
* in fase di sviluppo
Vchemys® EVO
Professionalità in farmacia
gli standard qualitativi del laboratorio condensati in 20 cm3

i benefici di Vchemys® EVO 4.0 per te farmacista.

Centrifugazione
per risultati esatti

Verifica l'idoneità del cmapione
(indice del siero)

Prepara i reagenti
disponibili per valutare
il funzionamento
dell’intero sistema

Verifica la bontà dei reagenti
(bianco reagente)

Controlla L'intero processo di analisi

Rilascia il report
con eventuale segnalazione
di valori anonimali
basta un click! Semplice, veloce senza pensierie

Utilizzabile subito
dopo l’accensione

semplicità d'uso
Solo 3 passaggi:
– Prelievo capillare
– Riempimento rotore
– Avvio test
Stessa procedura per tutti i rotori Ridotta possibilità di errore

ELEVATA CONNETTIVITà
WI-FI e 2 porte USB

i benefici di Vchemys® EVO 4.0 per i tuoi utenti.

ACCESSIBILITA’ AL SERVIZIO

RISULTATI RAPIDI

Elevata convenienza economica
Rotori Vchemys® UN CAPOLAVORO DI INGEGNERIA DA OGGI IL ROTORE SI DIVIDE IN 3
AMPIO PANNELLO DI TEST
Rotore dal design innovativo Oltre 40 test, suddivisi per profili d’organo, per soddisfare le diverse esigenze dei pazienti che possono scegliere tra una vasta gamma di opzioni : dal pannello biochimico di base per un check up generale, al profilo elettrolitico, cardiaco, renale, epatico, coagulativo e molti altri con soli 60 o 100 μL di sangue intero capillare.
FLESSIBILITÀ OPERATIVA
Rotori ampi che offrono fino a 24 test contemporaneamente per check up completi, oppure i nuovi rotori a spicchi con mini-profili per indagini diagnostiche mirate con soli 60 μL di campione (da 3 a 9 parametri).

ECONOMICITà D’ESERCIZIO
Zero manutenzione. Reagenti in confezioni da 10 test ciascuna.
Testi competitivi paragonabili al laboratorio, <1 € a test.

SICUREZZA DEI RISULTATI
Sono applicati gli stessi criteri di analisi dei laboratori. Lo strumento può lavorare su
siero | plasma | sangue intero capillare e venoso. IQC per monitorare le procedure di analisi VEQ per monitorare le performance della farmacia verso il laboratorio.

TRANQUILLITà DEL SERVIZIO
Assistenza Tecnica online con VODENEASYNET per supportarti in ogni momento.

Un modo intelligente e conveniente per personalizzare il profilo diagnostico e offrire sempre la soluzione perfetta per ogni paziente!

L’esigenza di far bene con il partner giusto

Controlli di qualità interni (IQC) della strumentazione in uso:
Controlli elettronici e campioni a titolo noto per controllare le tue procedure.

Valutazione Esterna di Qualità (VEQ):
in collaborazione con l’Azienda Ospedaliero Universitaria Careggi di Firenze, è stato sviluppato un programma di controllo della qualità super partes per confrontare le tue performance analitiche con quelle dei laboratori di analisi pubblici e privati.

Manutenzione programmata annuale
con verifica hardware e software degli strumenti con relativo rilascio di certificato di rispondenza alle specifiche di produzione.

NON SOLO UN SW GESTIONALE
per invio dati al PC, storicizzazione dei pazienti e la stampa personalizzata del report in formato A4, conforme alle nuove disposizioni di legge, ma un sistema pensato per offrire anche un’assistenza tecnico-applicativa continua, con il team Voden sempre disponibile online, 7 giorni su 7, pronto a supportarti in ogni momento!

In più, scegliendo Voden hai accesso all’Academy
la piattaforma esclusiva, dedicata ai nostri clienti, che mette a tua disposizione materiali, documenti, manualistica, certificazioni e video tutorial a supporto, per un continuo e comodo aggiornamento da remoto.
Non solo, è previsto inoltre il rilascio di un attestato di addestramento all’utilizzo della strumentazione a superamento di un questionario. team Voden sempre disponibile online, 7 giorni su 7, pronto a supportarti in ogni momento!
La diagnostica in farmacia è un servizio prezioso
che continuerà a migliorare e ampliarsi.
Ma richiede attenzione, competenza e strumenti professionali affidabili. Grazie a Voden, puoi contare su un sostegno tecnico-scientifico d’eccellenza che ti permette di affrontare il cambiamento con tranquillità, senza correre rischi.
Scegli l’evoluzione, scegli la sicurezza. Scegli Voden.
Richiedi informazioni sulla linea di diagnostica di prima
istanza NPT VODEN
informazioni
